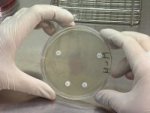
Resistenz-Test ©SWR

Folge 3: Saboteure in Aktion - AIDS, die weltweite Seuche
Timecode-Liste
- AIDS - eine Seuche geht um die Welt
- Bis 1983 dauerte es, bis der Erreger der Immunschwächekrankheit AIDS identifiziert war. Nach wie vor fordert das Virus viele Todesopfer. Wer an AIDS erkrankt, muss mit dem Gedanken leben, dass das Leiden zwar behandelbar, aber nicht heilbar ist.
- HIV attackiert das Immunsystem
- HI Viren zerstören wichtige Zellen des Immunsystems, auf die der Körper bei der Abwehr von Krankheitserregern dringend angewiesen ist. Die Attacke der HI-Viren schwächt die Patienten. Viele können nicht mehr arbeiten. Zu der lebensbedrohenden Erkrankung kommt oft noch der soziale Abstieg.
- Die Strategie der HI-Viren
- HI-Viren schleusen ihre Erbinformation in Zellen des Immunsystems ein, um sich zu vermehren. Angriffsziele sind vor allem Fresszellen und T-Helferzellen, die nach der Virusinvasion zugrunde gehen.
Trickfilm "Die Strategie der HI-Viren" starten
(Länge: 2:48 min)
- Beispiele für AIDS Therapien
- Mit verschiedenen Wirkstoffen lässt sich die Vermehrung von AIDS-Viren hemmen. Forscher haben eine Reihe von Gegenstrategien entwickelt.
- Das Stigma HIV-Positiv
- Da HI-Viren überwiegend durch Sexualkontakte übertragen werden, haben die Infizierten mit Vorurteilen zu kämpfen. Viele erleiden gesellschaftliche und berufliche Nachteile. Die historische Parallele zur Syphilis und anderen "Geschlechtskrankheiten" ist unübersehbar.
- Impfstoffe gegen HI-Viren
- Weltweit wird an Impfstoffen gegen HI-Viren geforscht. Die Hoffnung gründet sich auf Tierversuche mit Affen, bei denen die Schutzimpfung gegen ein ähnliches Virus erfolgreich war.
Trickfilm "Impfstoffe gegen HI-Viren" starten
(Länge: 0:22 min)
- AIDS in Afrika
- Die Staaten Afrikas sind am schlimmsten von der AIDS-Epidemie bedroht. Sexualverhalten, mangelnde medizinische Aufklärung und Versorgung tragen zur Verbreitung der Viren bei. Die Sterblichkeit, vor allem auch bei jüngeren Menschen ist so hoch, dass das soziale Gefüge zu zerbrechen droht und die wirtschaftliche Not zunimmt.
- AIDS und Prostitution
- Wie in Afrika, trägt auch in Asien die Prostitution zur Verbreitung von AIDS bei. Vor allem junge Menschen, manche noch im Kindesalter, sind Opfer und Ansteckungsquellen zugleich. Ohne ausreichende Bildung und berufliche Qualifikation sehen viele nur im Sexgewerbe ihr Auskommen. Staatliche Ausbildungsprogramme sollen Alternativen bieten.
- Gefahr durch resistente Erreger
- Die Erfahrung lehrt, dass ursprünglich hochwirksame Medikamente irgendwann ihre Schutzwirkung verlieren. Beispiel: Antibiotika. Auch gegen das beste Mittel können Krankheitserreger resistent werden.
Inhalt
Die Sendung beschäftigt sich mit der Infektionskrankheit AIDS, die sich seit ihrer Entdeckung weltweit ausgebreitet hat.Die Infizierten leiden nicht nur an den zum Teil schweren Krankheitssymptomen, sondern auch unter der Ausgrenzung durch Teile der Gesellschaft. AIDS wird in erster Linie bei Sexualkontakten übertragen.
Das AIDS Virus zerstört wichtige Zellen des Immunsystems und macht die Infizierten wehrlos gegen eine Vielzahl anderer Krankheitserreger. Dieser Vorgang ist in einer Trickdarstellung ist zu sehen.
Es gibt eine Reihe von chemischen Substanzen, welche die Vermehrung der Viren aufhalten. Wie diese Substanzen wirken, wird ebenfalls im Trick gezeigt. Als besonders wirksam hat sich die Kombinationstherapie erwiesen. Diese beugt einer Resistenzbildung gegen einen einzelnen Wirkstoff vor.
Forscher in aller Welt suchen nach einem Impfstoff gegen die HI-Viren. Zwar gibt es ermutigende Befunde in Tierversuchen. Doch beim Menschen wurde noch kein entscheidender Durchbruch erzielt.
Der beste Schutz vor AIDS ist die Aufklärung. Wie kann man sich vor einer Ansteckung schützen? Auch auf diese Frage geht die Sendung ein.
Weit mehr als Industrienationen sind Entwicklungsländer von der AIDS-Epidemie betroffen. Mangelnde Aufklärung und Prostitution tragen zur Verbreitung des Virus bei. Beispielhafte Ausbildungs- und Beschäftigungsprojekte versuchen den Menschen eine einträgliche Alternative zur Prostitution zu bieten.